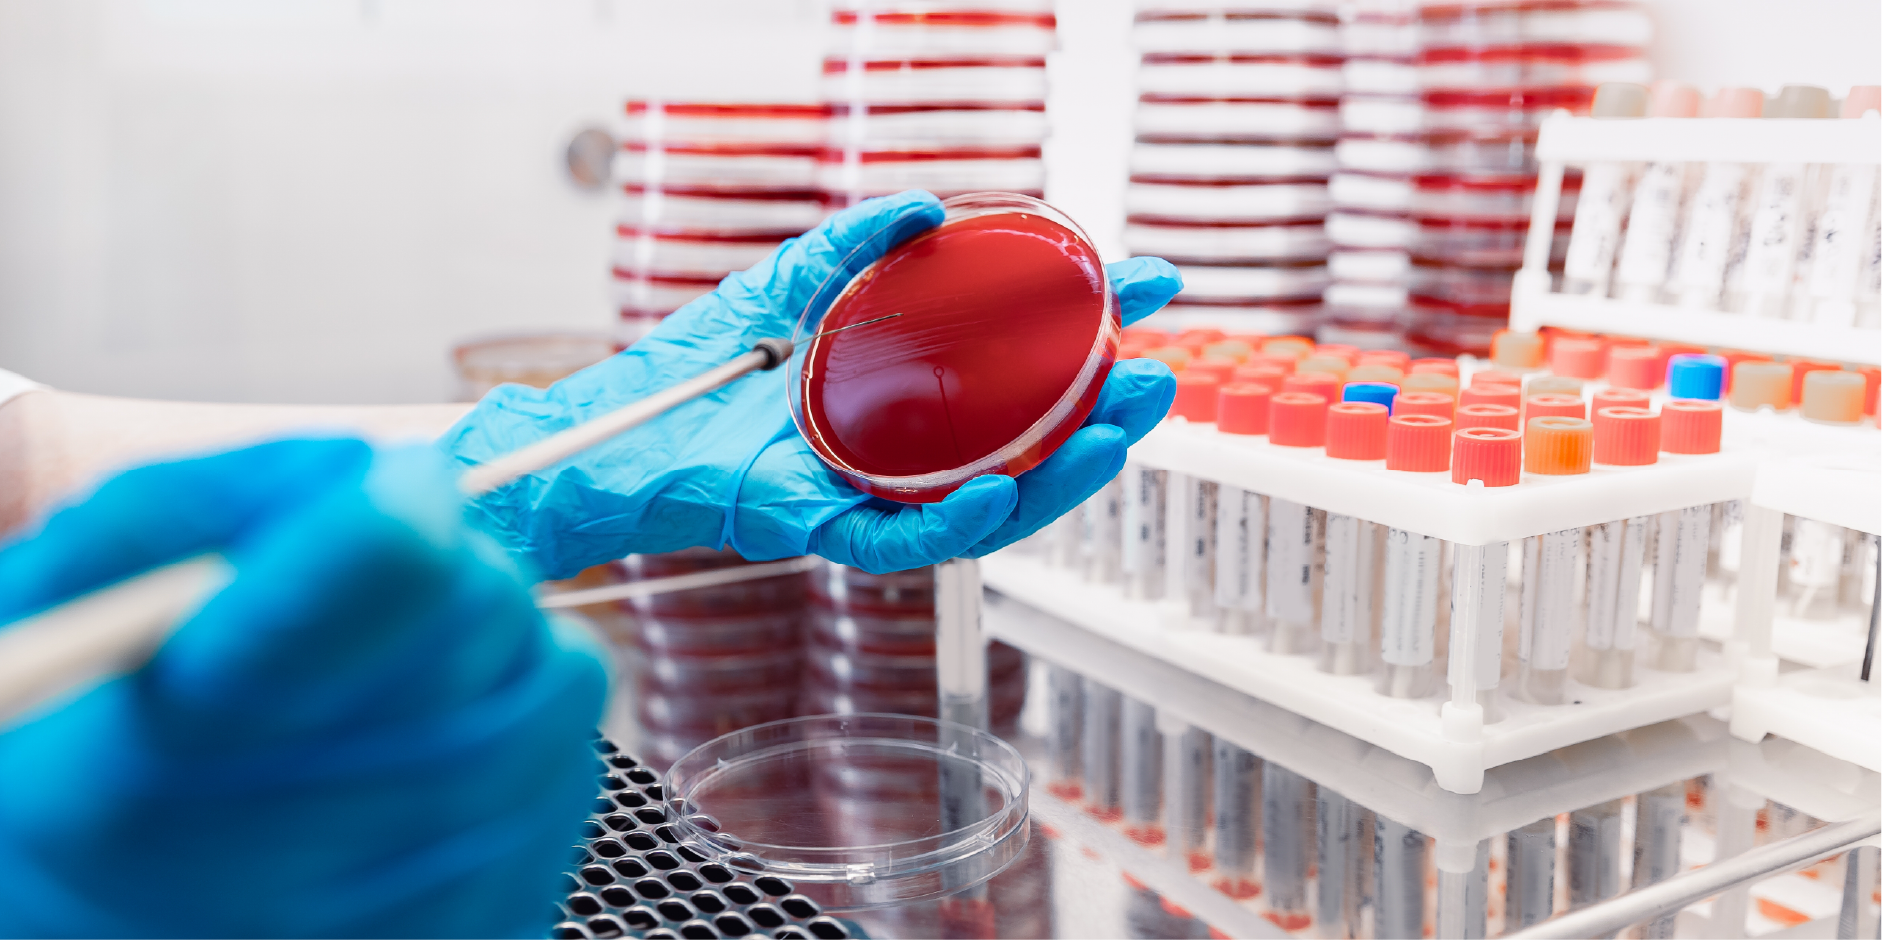
Pneumonia - Hospital-Acquired : Diagnostics | MIMS Singapore

روز جهانی ذاتالریه (World Pneumonia Day)

ذاتالریه یا پنومونی یکی از شایعترین و در عین حال خطرناکترین عفونتهای دستگاه تنفس تحتانی است. علائم معمول آن شامل تب، سرفه، خلط، درد قفسه سینه و تنگی نفس است.
میکروب های متفاوتی عامل ذات الریه هستند. اگر چه بعضی از این میکروب ها شایع و تشخیص آن ها آسان است، اما در مواردی تشخیص عامل بیماری بسیار مشکل می باشد. عفونت ریه میتواند در اثر باکتری، ویروس یا قارچ ایجاد شود. در اغلب موارد باکتریها عامل اصلی ایجاد بیماری هستند.
میکروبهایی که سبب ذاتالریه میشوند میتوانند از شخصی به شخص دیگر منتقل شوند. پنومونی ویروسی و باکتریایی میتواند از طریق استنشاق عطسه یا سرفه فرد آلوده و تماس با سطوح آلوده منتقل شود و مسری است.
درمان پنومونی به نوع ذاتالریه، شدت و سلامت عمومی فرد بستگی دارد، معمولا آنتیبیوتیکهای خوراکی، استراحت، مسکن معمولی و مایعات برای بهبود کامل بیماری پنومونی کافی است. افرادی که دارای وضعیت پزشکی خاص هستند، سالمندان و کودکان نیاز به مراقبتهای بیشتری و گاه بستری در بیمارستان دارند.
روز جهانی ذاتالریه هر سال در ۱۲ نوامبر (۲۱ آبان) گرامی داشته میشود تا توجه جهانیان به پیشگیری، تشخیص زودهنگام و درمان مؤثر این بیماری جلب شود. با وجود پیشرفتهای پزشکی، ذاتالریه همچنان از علل مهم مرگومیر کودکان زیر پنج سال و افراد سالمند است. بر اساس داده های سازمان جهانی بهداشت (WHO)، سالانه بیش از ۲.۵ میلیون نفر در جهان به علت این بیماری جان خود را از دست میدهند که حدود ۷۰۰ هزار نفر از آنها کودکان هستند (WHO, 2024).
آزمایشگاه؛ قلب تپنده در تشخیص و درمان ذاتالریه

اهمیت تشخیص دقیق و نقش آزمایشگاه
تشخیص بالینی ذاتالریه بر اساس علائم و معاینه فیزیکی انجام میشود، اما تأیید قطعی، تعیین عامل بیماریزا و ارزیابی شدت آن تنها از طریق آزمایشهای آزمایشگاهی و تصویربرداری قفسه سینه امکانپذیر است.
آزمایشگاه با ارائه نتایج دقیق در حوزههای هماتولوژی، بیوشیمی، میکروبیولوژی و روشهای مولکولی، نقشی حیاتی در هدایت درمان، انتخاب آنتیبیوتیک مناسب و پایش پاسخ به درمان ایفا میکند.
انواع آزمایشهای آزمایشگاهی در تشخیص ذاتالریه
۱. آزمایشهای عمومی و التهابی
- شمارش کامل سلولهای خونی : (CBC) افزایش نوتروفیلها معمولاً به نفع عفونت باکتریایی است، در حالی که لنفوسیتوز میتواند به نفع منشأ ویروسی باشد.
- CRP و : ESR افزایش این شاخصها بیانگر التهاب سیستمیک است و در افتراق ذاتالریه با سایر بیماریهای تنفسی مفید است.
- پروکلسیتونین (Procalcitonin) : یکی از مارکرهای اختصاصیتر برای عفونتهای باکتریایی است. مقادیر بالای آن با شدت بیشتر بیماری و نیاز به آنتیبیوتیک ارتباط دارد (Schuetz et al., 2017).
۲. آزمایشهای میکروبیولوژیک
هدف این آزمایشها شناسایی عامل عفونی و تعیین حساسیت دارویی آن است.
- کشت خلط: (Sputum culture) رایجترین روش برای تشخیص پاتوژنهای باکتریایی مانند Streptococcus pneumoniae ، Haemophilus influenzae و Staphylococcus aureus کشت خلط است.
- کشت خون: در بیماران بستری یا موارد شدید انجام میشود. گرچه حساسیت آن پایین است (حدود ۱۰–۲۰٪)، اما مثبت شدن آن اهمیت بالینی زیادی دارد.
- آزمایش آنتیژن ادراری: برای تشخیص سریع S. pneumoniae یا Legionella pneumophila مفید است.
- اسمیر و رنگآمیزی گرم: روش سریع و کمهزینه برای مشاهده مستقیم باکتریها در نمونه خلط.

۳. آزمایشهای مولکولی (PCR) و پانلهای Syndromic
در سالهای اخیر، فناوریهای تشخیصی مولکولی بهویژه PCR چندگانه (Multiplex PCR)، تحول بزرگی در تشخیص سریع ذاتالریه ایجاد کردهاند.
یکی از این فناوریها، BioFire FilmArray Pneumonia Panel است که میتواند بیش از ۳۳ پاتوژن (باکتری و ویروس) و چندین ژن مقاومت آنتیبیوتیکی را در کمتر از ۱ ساعت شناسایی کند (bioMérieux, 2023).
این روشها در بیماران بستری در ICU یا دارای ذاتالریههای مقاوم، ارزش تشخیصی بسیار بالایی دارند.
۴. آزمایشهای بیوشیمیایی و ارزیابی شدت بیماری
در بیماران بستری، آزمایشهای زیر برای تعیین وضعیت عمومی و شدت بیماری ضروری است :
- BUN و کراتینین : برای ارزیابی عملکرد کلیه، بهویژه در بیمارانی که داروهای نفروتوکسیک مصرف میکنند.
- الکترولیتهاNa⁺) (K⁺و : بهویژه در بیماران دچار دهیدراتاسیون یا شوک سپتیک.
- AST و : ALT برای بررسی عملکرد کبد.
- گازهای خون شریانی: (ABG) جهت ارزیابی سطح اکسیژن و دیاکسید کربن در خون.
نکته: بر اساس شاخص بالینی CURB-65، مقادیر بالای (BUN > 19 mg/dL) یکی از معیارهای بستری بیمار است (Lim et al., 2003).
۵. نوآوریهای جدید در تشخیص
در سالهای اخیر استفاده از آزمایشهای Point-of-Care و الگوهای هوش مصنوعی در تحلیل دادههای آزمایشگاهی مورد توجه قرار گرفته است. این ابزارها میتوانند در محیطهای کممنبع به تشخیص سریعتر کمک کنند.
همچنین ترکیب دادههای آزمایشگاهی با تصویربرداری قفسه سینه در الگوریتمهای یادگیری ماشین، دقت تشخیص را تا ۹۵٪ افزایش داده است (Chen et al., 2021).

سخن آخر
روز جهانی ذاتالریه یادآور اهمیت حیاتی پیشگیری، واکسیناسیون و تشخیص زودهنگام است. در این میان، آزمایشگاههای تشخیص طبی نقشی کلیدی در شناسایی عامل عفونت، پایش روند درمان، و جلوگیری از مصرف بیرویه آنتیبیوتیکها دارند.
مرکز تخصصی راز شیراز، یکی از بهترین آزمایشگاههای شیراز برای انجام این آزمایش ها است. نتایج آزمایشها در این مرکز با رعایت دقیق کلیه استانداردها، دارای حداکثر دقت است. تخصص و مهارت نیروهای تیم راز، و کیفیت و دقت دستگاههای بکار رفته در آزمایشگاه راز، آن را تبدیل به یکی از مجهزترین مراکز آزمایشگاهی بخش خصوصی دراستان فارس کرده است.
همکاران ما در آزمایشگاه راز شیراز با شماره تلفنهای 07132369393-6 و یا از طریق واتساپ با شماره 09914444130 منتظر دریافت سؤالات و راهنمایی شما در این زمینه هستند.
منابع (References)
1. World Health Organization (WHO). Pneumonia Fact Sheet (2024
2. Stop Pneumonia Initiative. World Pneumonia Day 2024. https://stoppneumonia.org/latest/world-pneumonia-day-2024
3. Schuetz, P. et al. (2017). Procalcitonin to initiate or discontinue antibiotics in acute respiratory tract infections. Cochrane Database Syst Rev, 10: CD007498.
4. Lim, W.S. et al. (2003). Defining community-acquired pneumonia severity on presentation: the CURB-65 score. Thorax 58(5): 377–382.
تهیه کننده :
مرضیه آزاد ، کارشناس ارشد ایمنی شناسی پزشکی -واحد تحقیق و توسعه آزمایشگاه پاتوبیولوژی راز